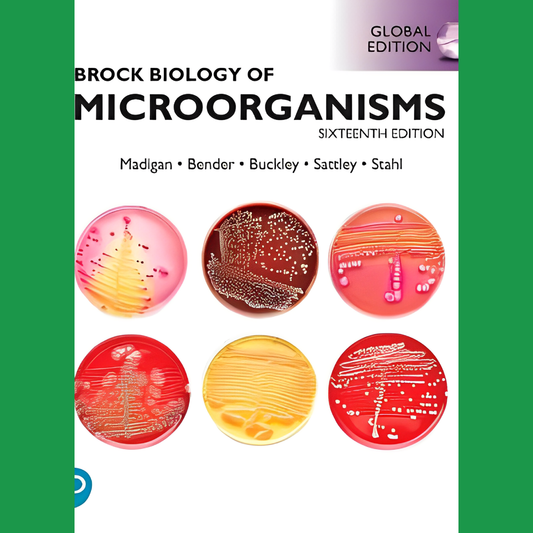
3e Bachelor: Brock Biology of Microorganisms - M. T. Madigan

SHOP
Wat moet je kopen? Raadpleeg de ABC-lijsten.
-
2e Master: Leerboek Psychiatrie - Michiel W. Hengeveld
Normale prijs €93,50 EURNormale prijsEenheidsprijs / per -
3e Bachelor: Brock Biology of Microorganisms - M. T. Madigan
Normale prijs €80,00 EURNormale prijsEenheidsprijs / per -
 Uitverkocht
Uitverkocht3e Bachelor: Clinical Surgery - Henry
Normale prijs €59,50 EURNormale prijsEenheidsprijs / per -
3e Bachelor: Dermatovenereologie voor de eerste lijn - Sillevis
Normale prijs €98,00 EURNormale prijsEenheidsprijs / per -
3e Bachelor: Diagnostiek van alledaagse klachten - De Jongh et al.
Normale prijs €114,00 EURNormale prijsEenheidsprijs / per -
3e Bachelor: Diagnostische en therapeutische methodieken
Normale prijs €18,00 EURNormale prijsEenheidsprijs / per -
3e Bachelor: Farmacotherapie op maat - De Vries et al.
Normale prijs €56,50 EURNormale prijsEenheidsprijs / per -

3e Bachelor: Handboek Gynaecologie - Y. Jacquemyn, P. De Sutter, I. Vergrote, H. Depypere
Normale prijs €69,00 EURNormale prijsEenheidsprijs / per -
3e Bachelor: Handboek verloskunde - R. Devlieger, Y. Jacquemyn, M. Laubach, K. Roelens
Normale prijs €57,50 EURNormale prijsEenheidsprijs / per -
3e Bachelor: Heron-reeks: Hematologie - J.J.M.L. Hoffmann, H.K. Nieuwenhuis
Normale prijs €60,00 EURNormale prijsEenheidsprijs / per -
3e Bachelor: Keel-neus-oor-aandoeningen - A. De Sutter, I. Dhooge
Normale prijs €65,00 EURNormale prijsEenheidsprijs / per -
3e Bachelor: Kumar and Clark's Clinical Medicine - D. Randall, J. Booth, K. Wiles
Normale prijs €76,00 EURNormale prijsEenheidsprijs / per -
3e Bachelor: Mims' Medical Microbiology - H. Dockrell
Normale prijs €72,50 EURNormale prijsEenheidsprijs / per -
3e Bachelor: Ontwikkeling, voortplanting en verloskunde (histologie)
Normale prijs €5,00 EURNormale prijsEenheidsprijs / per -
3e Bachelor: Principles and Practice of Infectious Diseases - G. L. Mandell
Normale prijs €62,50 EURNormale prijsEenheidsprijs / per -
3e Bachelor: Robbins & Cotran Pathologic Basis of Diseas - V. Kumar, A.Abbas, J. Aster
Normale prijs €130,00 EURNormale prijsEenheidsprijs / per
ONZE SPONSERS
1
/
van
4